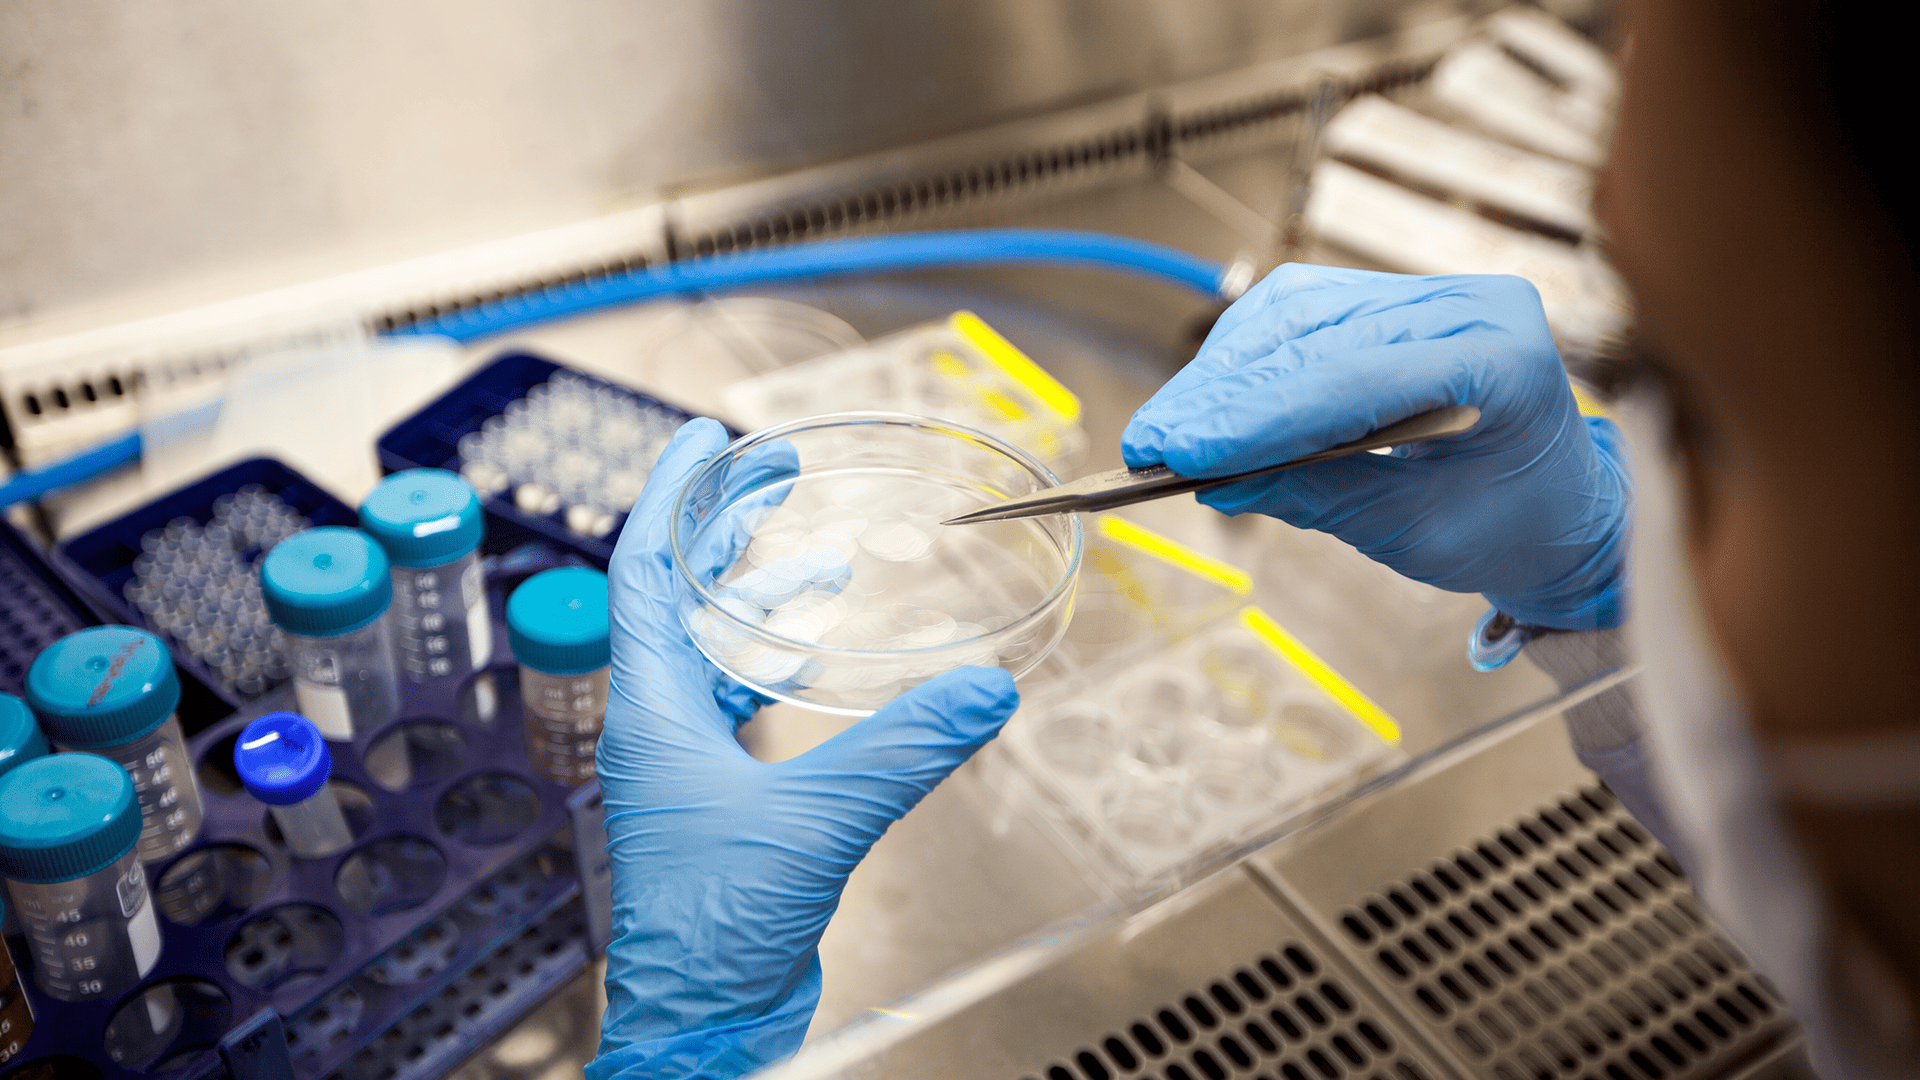
Researcher in the lab

OVERVIEW
The Centre for Active Living is at the forefront of research dedicated to transforming how we prevent, treat, and manage health challenges in today’s evolving world. From harnessing cutting-edge technologies to develop breakthrough treatments for non-communicable and infectious diseases, to reimagining healthcare through digital innovation and interdisciplinary collaboration, the Centre is driven by a bold vision for the future of well-being.
Our researchers are advancing the science of active ageing, functional nutrition, and regenerative medicine to tackle pressing issues such as diabetes and age-related complications—empowering individuals not just to live longer, but to live better.